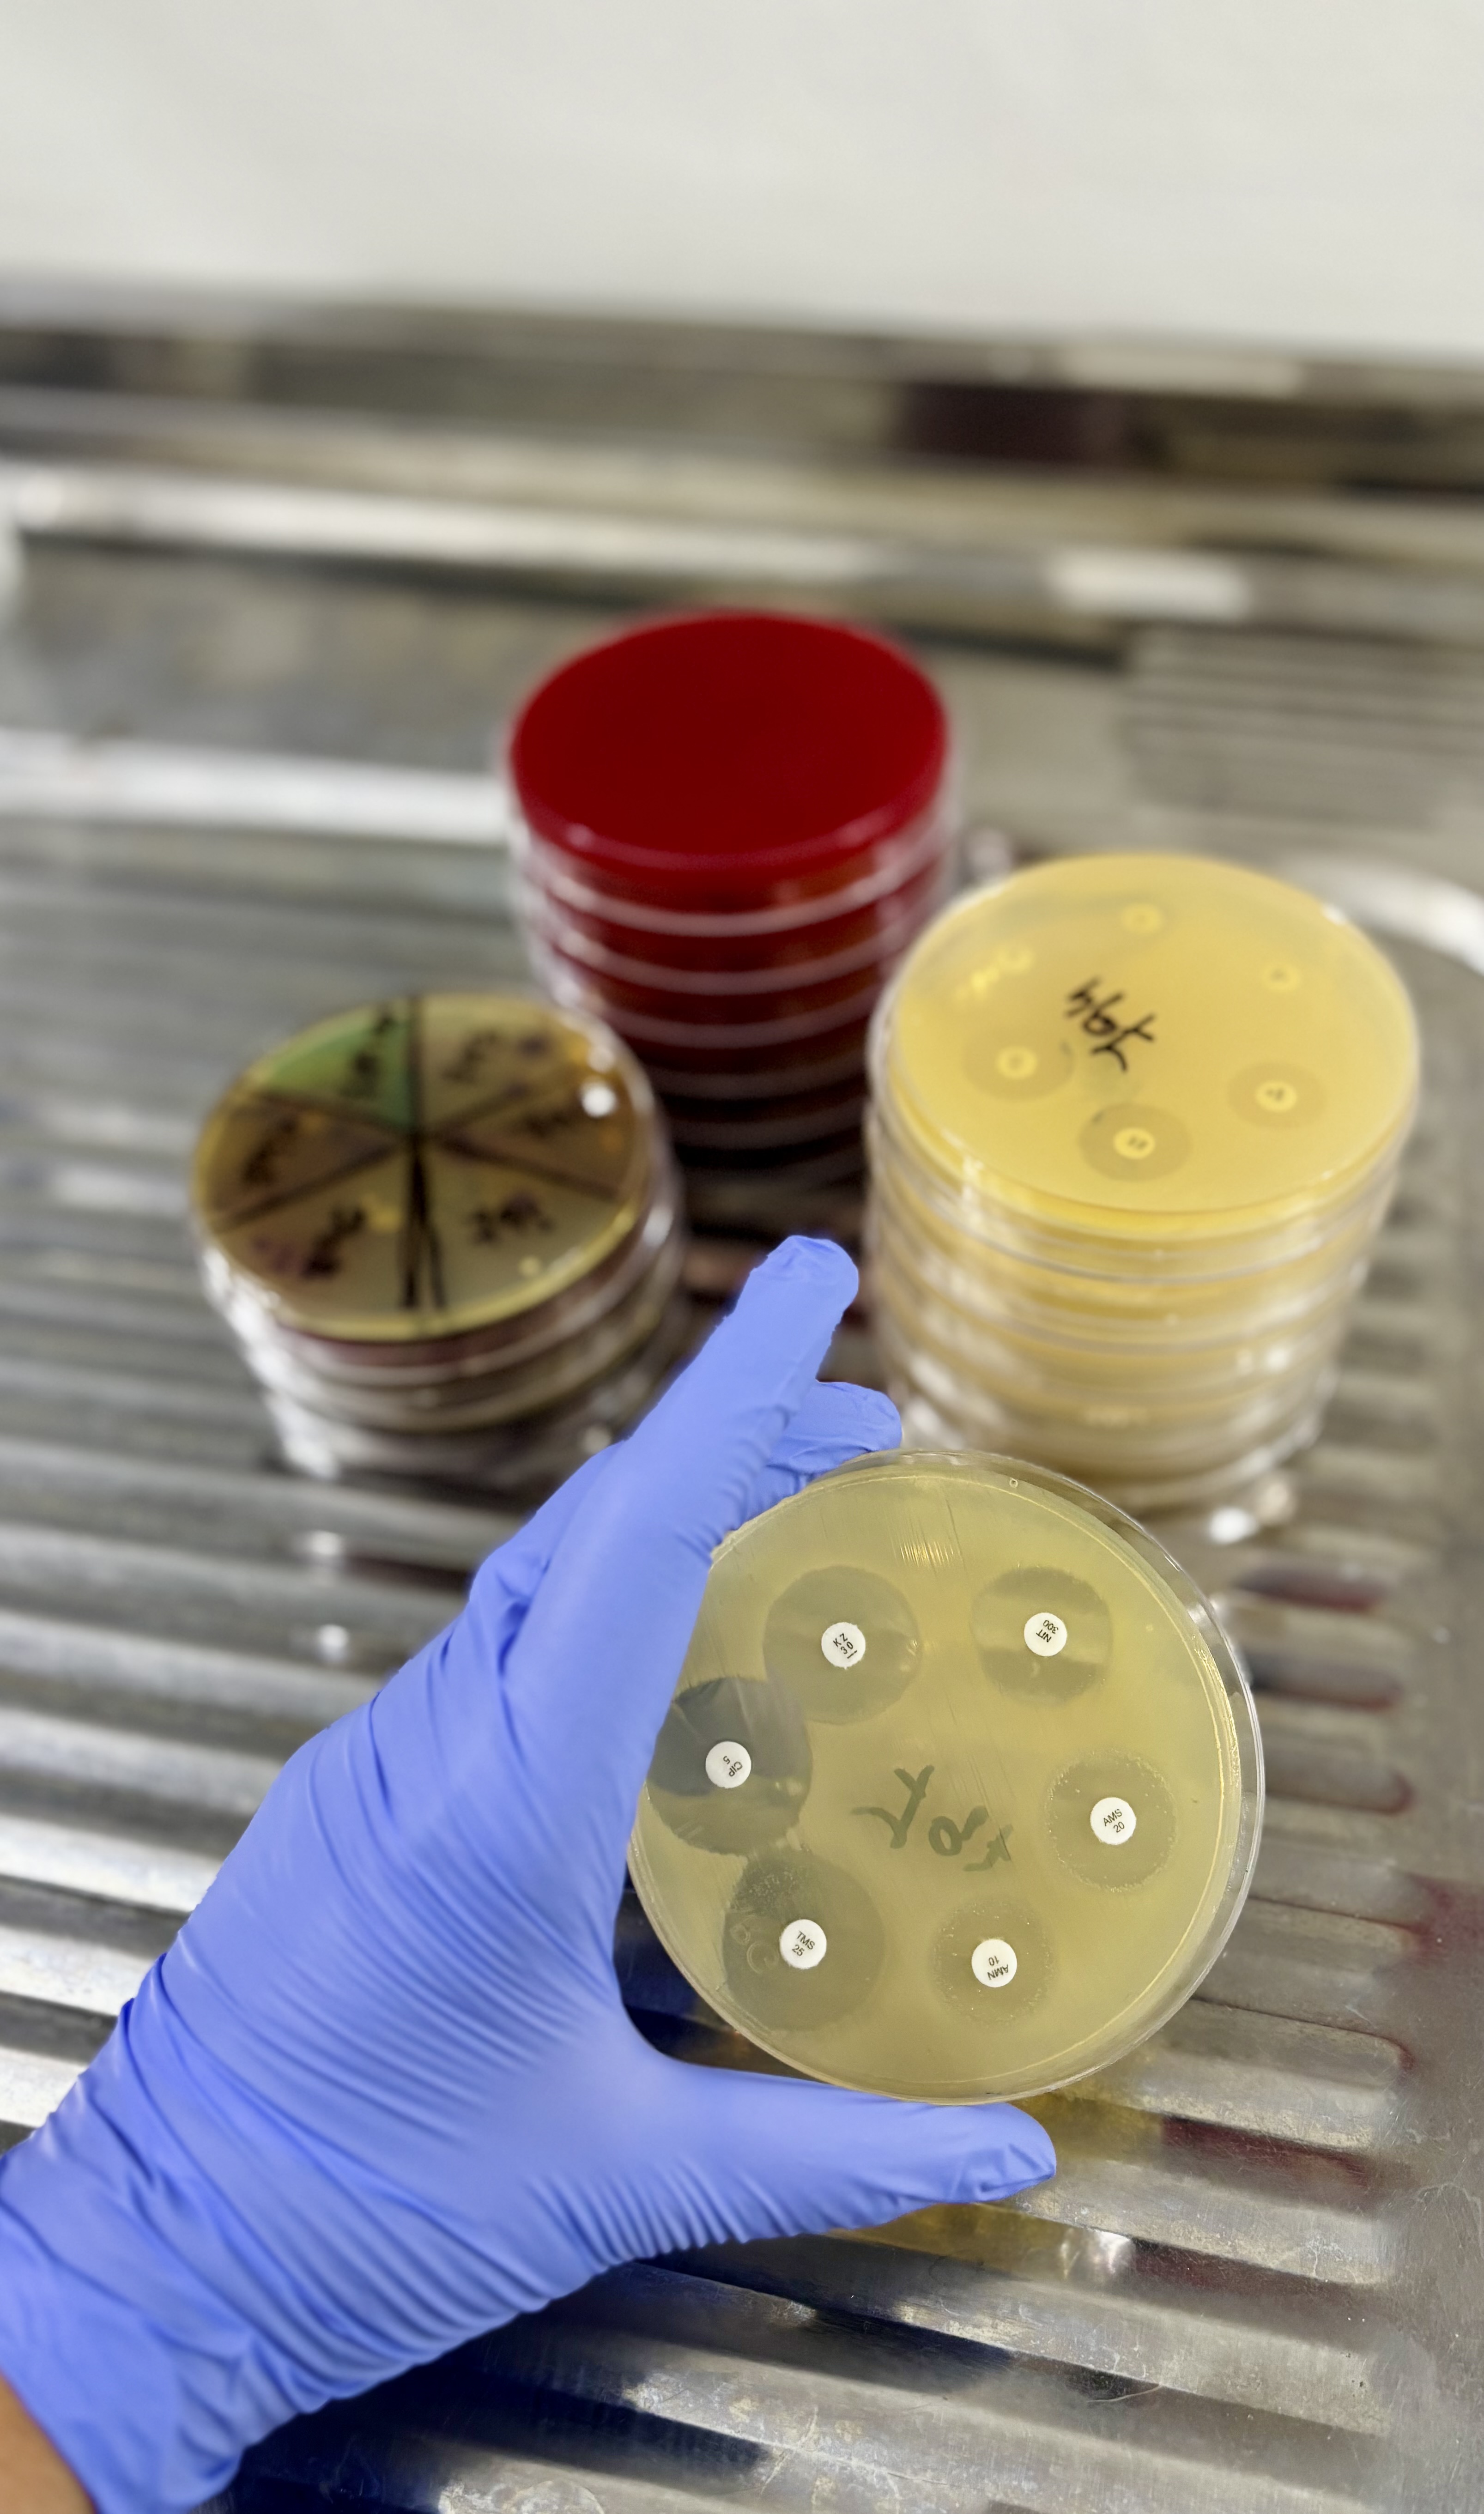

Los análisis clínicos son de valiosa utilidad para confirmar o descartar un diagnóstico médico. Un chequeo periódico es muy importante para detectar diferentes padecimientos de manera temprana.

Los análisis endocrinológicos permiten evaluar el correcto funcionamiento del sistema hormonal del organismo. A través de estudios específicos es posible detectar alteraciones en glándulas como la tiroides, hipófisis, suprarrenales, páncreas y gónadas.
La fertilidad de una persona puede verse afectada por diferentes factores como la edad, la aparición de patologías, etc. Gracias al avance de la ciencia actualmente existen diversos tratamientos para protegerla.

Realizamos estudios para detectar, identificar y cuantificar bacterias responsables de infecciones en el organismo. A través de cultivos y antibiogramas brindamos información precisa para elegir el tratamiento antimicrobiano más adecuado y efectivo.
Al momento de incorporar personal toda empresa debe realizar un examen pre-ocupacional que asegure que el postulante reúne las condiciones psicofisicas que su trabajo requerirá.
Realizamos análisis Bacteriológico y Fisicoquímico de aguas subterráneas, superficiales, de riego, de napas freáticas, y de uso industrial según se requiera cada caso.

Somos profesionales bioquímicos con más de 40 años de experiencia en análisis clínicos, comprometidos con contribuir al diagnóstico médico y al seguimiento de enfermedades mediante resultados precisos y confiables. Brindamos una atención cálida, eficiente y personalizada, adaptándonos a los cambios sociales, económicos y tecnológicos; con el objetivo de sostener la calidad que nos define.
Cargando…
